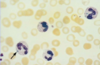
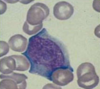
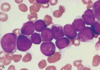
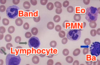
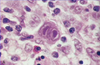

Pathology-White Cell Disorders Flashcards
(82 cards)
A 9 year old presents with persistent severe eczema and superficial skin pustules. Physical exam reveals lymphadenopathy. Labs show eosinophilia. Lymph node biopsy shows scattered rare large cells with prominent nucleoli in a background of normal appearing lymphocytes. What is your diagnosis?
Non-classic Hodgkin’s lymphoma.
What are causes of low white count?
Leukopenia is caused by marrow failure, aplastic anemia, chemotherapy, drugs, hyper or hypo cellular bone marrow and infections.
What are causes of a high white count?
Leukocytosis is caused by neutrophilia (infection/inflammation), eosinophilia (allergies, parasites, drugs, cancer), basophilia (CML), monocytosis (chronic infection, collagen vascular diseases), lymphocytosis (chronic infections, viral)
What are causes of leukemoid reaction?
Reactive leukocytosis can be caused by 30-50,000 granulocytosis (bacterial or myeloproliferative disease) or >10,000 lymphocytosis (viral, TB, sarcoid, leukemia or lymphoma)
What is the common abnormality of all the myeloproliferative diseases (CML/polycythemia vera)?
Abnormal tyrosine kinase
What does this indicate?
Doehle bodies are found in reactive neutrophils and are more commonly found in reactive diseases rather than neoplastic diseases.
What does this indicate?

This is reactive follicular hyperplasia. Note the sharp polarized mantle and “starry sky” appearance due to tingible body macrophages in the center of the lymph node gobbling up cells turning over in the germinal center.
A 14 year old girl comes to the clinic with a fever, sore throat and fatigue for the past month. On physical exam you note posterior cervical lymphadenitis. What would you expect to see on blood smear?
She has infectious mononucleosis from EBV. You would see atypical lymphocytes on blood smear because of the reactive T cell response to the viral infection.
What other virus follows a similar pattern as EBV?
CMV. It also will present as infectious mononucleosis.
A 14 year old girl comes to the clinic with a fever, sore throat and fatigue for the past month. On physical exam you note posterior cervical lymphadenitis. How did she get this condition?
EBV is transmitted orally. You 1st get IgM antibodies against the capsid, then you form IgG. Infection causes atypical (really large) cytotoxic T and NK lymphocytes activity against polyclonal B cell proliferation (hence the lymphadenopathy).
A 14 year old girl comes to the clinic with a fever, sore throat and fatigue for the past month. On physical exam you note posterior cervical lymphadenitis and hepatosplenomegaly. Her peripheral blood smear is shown below. Why do you think this is a reactive condition vs. a neoplastic condition?
Note the atypical lymphocyte skirting around the RBCs, this is not seen in neoplastic states, often seen in reactive states.
What are people with long-standing mono at risk for if they get into a car accident?
Spleen rupture. Splenomegaly thins the capsule wall and makes it more prone to rupture.
A 14 year old girl comes to the clinic with a fever, sore throat and fatigue for the past month. On physical exam you note posterior cervical lymphadenitis and hepatosplenomegaly. She is also on immunosuppressive therapy for juvenile arthritis. Her peripheral blood smear is shown below. What types of cancer is she at risk for?

EBV infection can cause a second hit mutation causing a translocation of 8:14 when patients are immunosuppressed. This can cause a proliferation of Burkitt lymphoma.

A kid gets scratched by a cat. Fine needle biopsy of his posterior cervical lymph nodes is shown below. What organism causes this and what is he at risk for developing?

The kid has Cat Scratch Disease from infection by Bartonella henselae. As the disease progresses you get stellate necrosis (shown below) in the lymph node germinal centers

Where are most neoplastic cells in leukemia?
Bone marrow and peripheral blood
Where are most neoplastic cells in lymphoma?
Lymph nodes
Where are most neoplastic cells in myeloma?
Bone marrow
Where are most neoplastic cells in Hodgkin’s disease?
Some in marrow, primarily in lymph nodes.
What precursor cells causes lymphoblastic lymphomas and leukemias?
Lymphoblasts (big immature B cells)

What precursor cells causes small lymphocytic lymphoma and chronic lymphocytic leukemia?
Naive B cells

What precursor cells cause mantle cell lymphomas?
Mantle cells.

Where do follicular, Burkitt, diffuse large B cell and Hodgkin’s lymphomas originate from?
Germinal centers

Where do diffuse large B cell, marginal zone and small lymphocytic lymphomas and chronic lymphocytic leukemias originate from?
Marginal zone

How do T-cells develop and progress in the thymus?
They start and double negatives, then they become double positive for CD4 and CD8. Then they mature into either a CD4 or CD8 T cells.